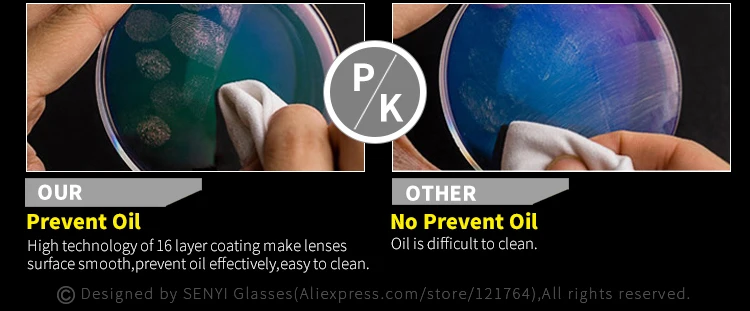

Новое поступление
Характеристики
*Текущая стоимость 2 077,86 - 2 935,24 уже могла изменится. Что бы узнать актуальную цену и проверить наличие товара, нажмите "Добавить в корзину"
| Месяц | Минимальная цена | Макс. стоимость | Цена |
|---|---|---|---|
| Feb-19-2026 | 2638.99 руб. | 2691.23 руб. | 2664.5 руб. |
| Jan-19-2026 | 2139.15 руб. | 2182.69 руб. | 2160.5 руб. |
| Dec-19-2025 | 2596.75 руб. | 2648.82 руб. | 2622 руб. |
| Nov-19-2025 | 2575.34 руб. | 2627.49 руб. | 2601 руб. |
| Oct-19-2025 | 2056.5 руб. | 2097.48 руб. | 2076.5 руб. |
| Sep-19-2025 | 2534.66 руб. | 2585.63 руб. | 2559.5 руб. |
| Aug-19-2025 | 2513.19 руб. | 2563.62 руб. | 2538 руб. |
| Jul-19-2025 | 2492.18 руб. | 2542.79 руб. | 2517 руб. |
Описание товара






![]()

Смотрите так же другие товары: